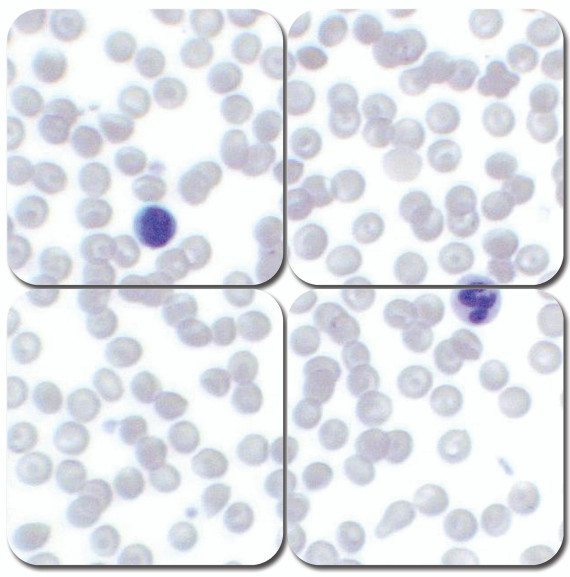
Wright-Giemsa Stain Kit, Pint

Description
Stains for blood and blood parasites in as little as 2 minutes. This procedure has been optimized for differential staining of blood smears and identifying blood parasites. Wrights-Giemsa Stain serves as the primary stain producing pink-tan red blood cells, bluish-purple white blood cells and leukocytes, light purple or lavender neutrophils, bright red granule eosinophils, deep purple or violet granule basophils and reddish-purple granule platelets.
The Wrights-Giemsa Stain kit includes a procedure for routine and stat staining and includes the necessary buffer.
Pint Stain Kit yields between 680-1000 slides.
Slide Yields assume maximum slides stained per run, maximum runs per use. Actual Slide Yields may vary.
Pint Kit Consists of: Wright-Giemsa Stain Pint and Phosphate Buffer 6.8 pH 3 Pints.